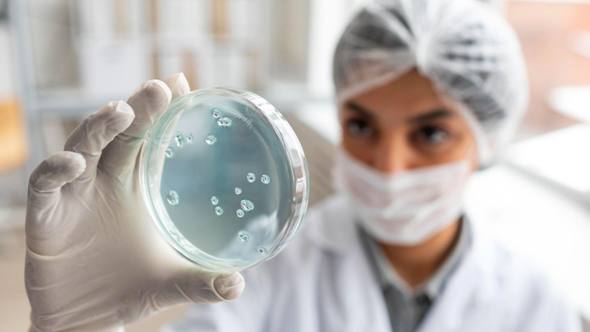

- Portada
- Noticias
- ActualidadAlergologíaCardiologíaCirugía estéticaDentista y salud dentalDermatologíaDigestivoEmbarazoFarmaciaFisioterapiaDentista y salud dental
Desgaste dental y envejecimiento de la sonrisa
Cómo podemos recuperar la función de nuestros dientes con tratamientos conservadores. Pocas cosas envejecen una cara tanto como una sonrisa desgastada y,...Actualidad¿Qué es la alimentación cardiosaludable y cómo puede beneficiar a tu corazón?
¿Sabías que lo que comes diariamente tiene un impacto directo en la salud de tu corazón? Según un informe de la...ActualidadCampaña con 14 claves para prevenir el cáncer
Coincidiendo con el Día Mundial contra el Cáncer, que se conmemora cada 4 de febrero, la Asociación Española Contra el Cáncer...
- Actualidad
- Actualidad
¿Qué es la alimentación cardiosaludable y cómo puede beneficiar a tu corazón?
¿Sabías que lo que comes diariamente tiene un impacto directo en la salud de tu corazón? Según un informe de la...ActualidadCampaña con 14 claves para prevenir el cáncer
Coincidiendo con el Día Mundial contra el Cáncer, que se conmemora cada 4 de febrero, la Asociación Española Contra el Cáncer...ActualidadTOP 5 tipos de seguros médicos privados según sus coberturas
Cuando uno empieza a mirar opciones de seguros médicos privados, es fácil perderse entre tantas modalidades y coberturas. Por eso, vale...ActualidadIdentifican de Compuestos Antitumorales en una Nueva Variedad de Berenjena
Un estudio realizado por la Universidad de Granada (UGR) y el ibs.GRANADA, en colaboración con la Fundación Cellbitec, ha demostrado la...
- Especiales
- Profesionales
- Contacto
- Portada
- Noticias
- ActualidadAlergologíaCardiologíaCirugía estéticaDentista y salud dentalDermatologíaDigestivoEmbarazoFarmaciaFisioterapiaDentista y salud dental
Desgaste dental y envejecimiento de la sonrisa
Cómo podemos recuperar la función de nuestros dientes con tratamientos conservadores. Pocas cosas envejecen una cara tanto como una sonrisa desgastada y,...Actualidad¿Qué es la alimentación cardiosaludable y cómo puede beneficiar a tu corazón?
¿Sabías que lo que comes diariamente tiene un impacto directo en la salud de tu corazón? Según un informe de la...ActualidadCampaña con 14 claves para prevenir el cáncer
Coincidiendo con el Día Mundial contra el Cáncer, que se conmemora cada 4 de febrero, la Asociación Española Contra el Cáncer...
- Actualidad
- Actualidad
¿Qué es la alimentación cardiosaludable y cómo puede beneficiar a tu corazón?
¿Sabías que lo que comes diariamente tiene un impacto directo en la salud de tu corazón? Según un informe de la...ActualidadCampaña con 14 claves para prevenir el cáncer
Coincidiendo con el Día Mundial contra el Cáncer, que se conmemora cada 4 de febrero, la Asociación Española Contra el Cáncer...ActualidadTOP 5 tipos de seguros médicos privados según sus coberturas
Cuando uno empieza a mirar opciones de seguros médicos privados, es fácil perderse entre tantas modalidades y coberturas. Por eso, vale...ActualidadIdentifican de Compuestos Antitumorales en una Nueva Variedad de Berenjena
Un estudio realizado por la Universidad de Granada (UGR) y el ibs.GRANADA, en colaboración con la Fundación Cellbitec, ha demostrado la...
- Especiales
- Profesionales
- Contacto
Biomedicina
Copyright © | Todos los derechos reservados.
Salud IDEAL pertenece a Corporación de Medios de Andalucía, S.A.
Responsable Legal: Corporación de Medios de Andalucía, S.A.
C.I.F.: A78865458
Dirección: Av. Huelva 2, Polígono de ASEGRA, 18210 Peligros (Granada)
Contacto: info@saludideal.es
Teléfono: 958 809 809
Datos Registrales: Registro Mercantil de Granada, folio 117, tomo 304 general, libro 204, sección 3ª sociedades, inscripción 4ª.